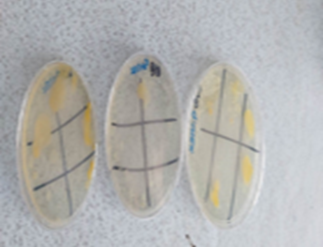

АРИУН ЦЭВРИЙН ЛАБОРАТОРИ: Тус лаборатори нь 13 аж ахуйн нэгж, хувиараа хөдөлмөр эрхлэгч иргэний 5,1 тонн махны 4,0 кг дээжинд MNS 6 стандарт, MNS ISO 8 стандартыг мөрдлөгө болгон маханд эрүүл ахуйн 4 шалгуур үзүүлэлт, аюулгүй байдлын 8 шалгуур үзүүлэлтээр шинжилгээг хийж гүйцэтгэлээ. Махны эрүүл ахуйн үзүүлэлтүүдэд бактерийн ерөнхий тоо, гэдэсний бүлгийн бактери буюу колиформын нийт тоог тоолох, аюулгүй байдлын шалгуур үзүүлэлтүүдэд Салмонелла 25гр-д үүсгэгч илрүүлэх, Клостридиум перфирингенс үүсгэгч илрүүлэх, гэдэсний бүлгийн савханцарын тоог тогтоох аргуудыг ашиглан хийж гүйцэтгэлээ. Мөн сүүний дээжинд аюулгүй байдлын Стафилооус ареус-ийг илрүүлэх, бруцелла илрүүлэх шинжилгээг, эрүүл ахуйн Бактерийн ерөнхий тоог тоолох, Гэдэсний бүлгийн бактери 1 мл-т тоолох аргуудаар шинжилгээг, Тахианы аж ахуйгаас ирсэн 2 удаагийн 10900 өндөгийг мэдэрхүйн үзлэг хийж 30 ширхэг өндөг дээжинд авч овоскопын аргаар болон нян судлалын шинжилгээг 17 үзүүлэлтээр хийж дүнг гарган батлагдсан стандарт, аргазүйн дагуу хийж гүйцэтгэн анхан шатны баримт бичиг болох журнал, дээжийн бүртгэл,тэжээлт орчныг бэлтгэх ажлуудыг хийж гүйцэтгэн лабораторийн эрхлэгчээр баталгаажуулан иргэн, аж ахуйн нэгжийн эздэд хүргүүлж ажилласан.Нийт 102 үзүүлэлтээр 192 сорьцод мах, өндөгний шинжилгээг хийж гүйцэтгэсэн байна.